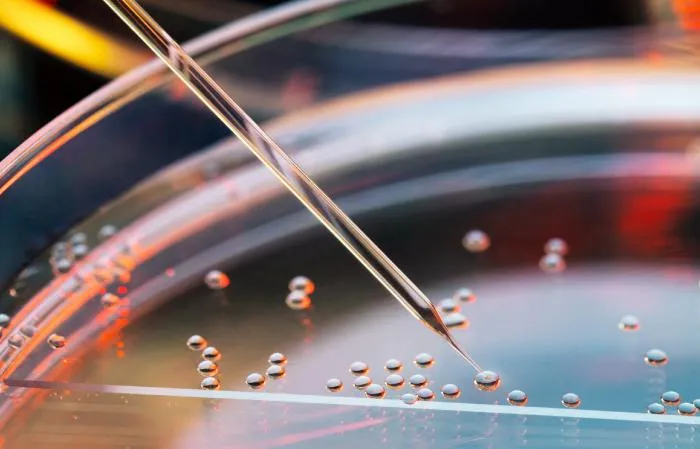

Под угрозой находятся тысячи видов, и клонирование потенциально может их спасти от вымирания
Остановленный прогресс
Главная проблема в том, что клоны – это нежизнеспособные существа. В ходе эксперимента с овечкой Долли были оплодотворены 277 яйцеклеток. До состояния эмбрионов развились 29 гамет. Из них выжил только один. Непосредственно сама Долли.
Прожила она вполовину меньше положенного природой срока: 6 лет вместо 12. В 4 года у животного диагностировали тяжелый артрит. Долли оказалась уязвима для инфекционных заболеваний и еще через 2 года была усыплена из принципа милосердия.

По сравнению с домашними овцами клонирование диких существ окажется сложнее. Ученые плохо понимают репродуктивную физиологию редких животных. Это делает рискованным процесс извлечения яйцеклеток или использование самки исчезающего вида для вынашивания клона. И без того редкий зверь может погибнуть при родах или стать в результате эксперимента бесплодным.
Упорные всесторонние исследования могли бы решить этот вопрос. Однако финансирование и поддержка подобных опытов ограничены из-за этических соображений.
Почему клоны не жизнеспособны?
На самом деле относительно жизнеспособны, если клонировать животных одного вида. Выживает каждый пятый эмбрион. Однако исчезающих животных нельзя клонировать внутри собственной популяции по причине их малочисленности и опасности им навредить.
Потребуется суррогатная мать близкородственного вида, которая будет вынашивать клон. Такие эмбрионы имеют ядерную ДНК клонированного вида и митохондриальную ДНК донорской яйцеклетки. Несоответствие генов делает проблематичным развитие плода в утробе.
Проблема в том, что гены ядерной и митохондриальной ДНК никогда не совпадают полностью. Даже если эмбрион получает развитие, плод получается слабым и неполноценным. Из нескольких сотен выживает один эмбрион. Та же овечка Долли была гибридом дорсетской и шотландской чернолицей овец.
Ещё одним изъяном технологии является то, что получаемый клон не является «чистым» животным. По факту это уже новый вид, гибрид. То есть мамонты, сумчатые волки, птицы додо и другие вымершие животные исчезли навсегда. Мы сможем лишь воссоздать их похожие копии, но не «оригинальные» виды
Возможность, отложенная на потом
Наука развивается со временем, появляются новые знания, открываются новые возможности. Поэтому не стоит ставить крест на клонировании. Если животных нельзя клонировать сегодня, то у человечества появится такая возможность в будущем.
Для этой цели с 2009 года Бразильская сельскохозяйственная исследовательская корпорация и Национальный Зоологический сад Бразилии начали собирать образцы ДНК редких животных и растений. Они уже успели собрать образцы 10 тысяч видов растений, а также 800 видов птиц и млекопитающих.

В 2000-х годах Университет Терамо в Италии успешно клонировал овцу муфлона – редкое жвачное животное. Институт природы Одюбона в США клонировали африканскую дикую кошку. Сеульский национальный университет в Корее вывели 3 исчезающих азиатских волка. Все особи дожили до зрелого возраста.
Вероятно, в будущем, когда власти будут больше выделять денег на науку, учёные все-таки начнут клонировать исчезающих животных. Быть может, человечество вновь увидит мамонтов и сумчатых волков. Однако это произойдёт явно нескоро.